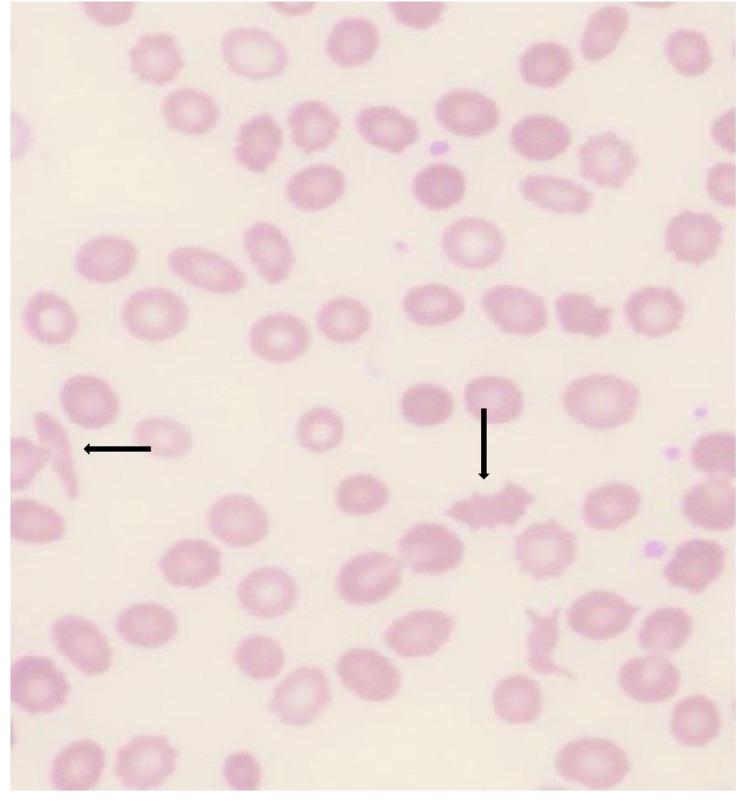
https://cdn.ncbi.nlm.nih.gov/pmc/blobs/055c/8934198/7114a09c0e9f/cureus-0014-00000023207-i01.jpg

由罕见的补体因子B突变引起的非典型溶血尿毒症综合征
Atypical Hemolytic Uremic Syndrome Caused by a Rare Complement Factor B Mutation.
作者信息
Bandaru Sai Samyuktha
机构信息
Internal Medicine, Baton Rouge General Medical Center, Baton Rouge, USA.
出版信息
Cureus. 2022 Mar 16;14(3):e23207. doi: 10.7759/cureus.23207. eCollection 2022 Mar.
Thrombotic microangiopathy (TMA), a rare and diagnostically challenging condition, commonly presents with a triad of thrombocytopenia, hemolytic anemia, and end-organ damage, such as renal failure. Most cases of the hemolytic uremic syndrome (HUS) are mediated by Shiga toxin-producing , but some cases present as an atypical HUS, which includes thrombotic thrombocytopenic purpura and complement-mediated thrombotic microangiopathy (C-TMA). Although C-TMA occurs because of genetic and acquired mutations in the complement regulatory factors, it is usually hereditary. The currently available treatment options include therapeutic plasma exchange and administration of eculizumab, which is a monoclonal antibody against C5. Here, we report a diagnostically challenging and extremely rare case of a middle-aged Caucasian man who was diagnosed with atypical HUS that was caused by a mutation in complement factor B. This case highlights the importance of not overlooking rare causes of TMAs because the diagnostic evaluation is important for guiding appropriate management and obtaining a favorable prognosis.
血栓性微血管病(TMA)是一种罕见且诊断具有挑战性的疾病,通常表现为血小板减少、溶血性贫血和终末器官损伤(如肾衰竭)三联征。大多数溶血性尿毒症综合征(HUS)病例由产志贺毒素介导,但有些病例表现为非典型HUS,包括血栓性血小板减少性紫癜和补体介导的血栓性微血管病(C-TMA)。虽然C-TMA是由于补体调节因子的遗传和获得性突变而发生,但它通常是遗传性的。目前可用的治疗选择包括治疗性血浆置换和使用依库珠单抗,后者是一种抗C5单克隆抗体。在此,我们报告一例诊断具有挑战性且极其罕见的病例,一名中年白人男性被诊断为非典型HUS,其病因是补体因子B突变。该病例强调了不忽视TMA罕见病因的重要性,因为诊断评估对于指导适当治疗和获得良好预后至关重要。